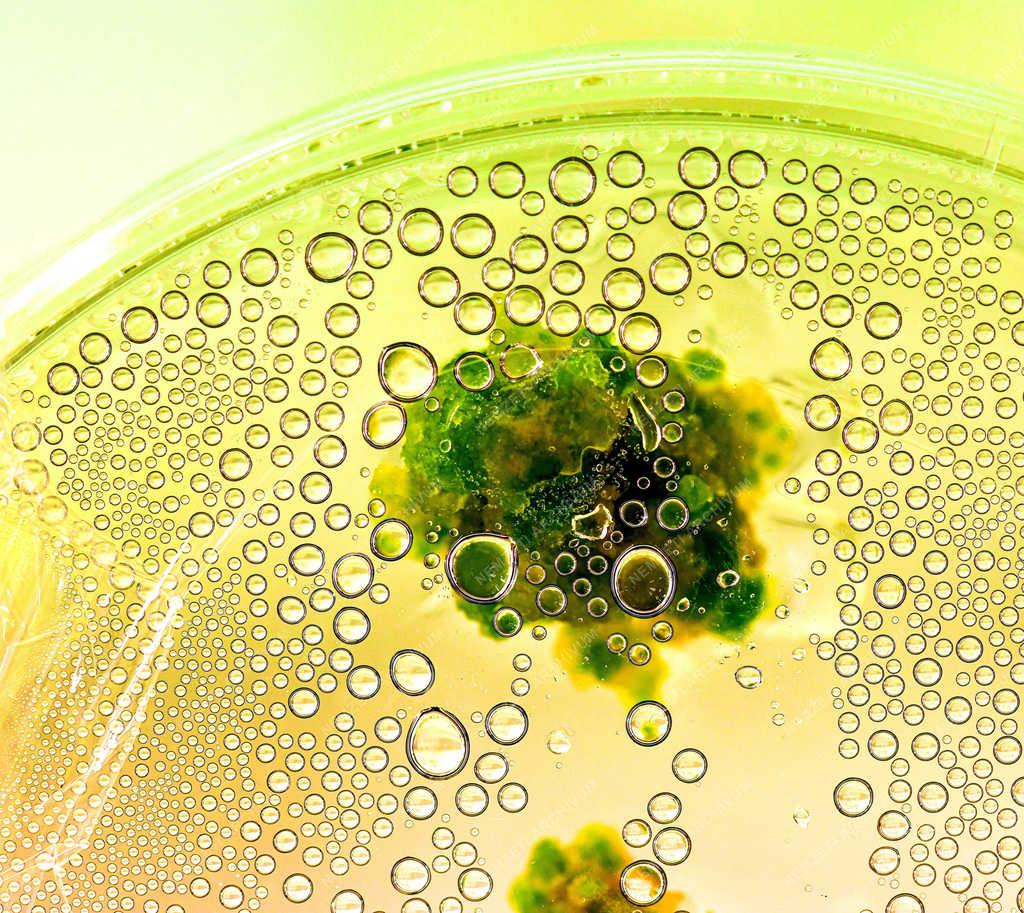

Nemzeti Fotótár
Megállítjuk az időt
Tudomány - Debrecen - Kitüntetett egyetemi gyógyszerész
Debrecen, 2021. február 17.
Növényi szövettenyészet. A Debreceni Egyetem TTK Növénytani Tanszékének kutató gyógyszerésze, Gonda Sándor habilitált adjunktus eddigi tevékenységét a Magyar Gyógyszerésztudományi Társaság Szász Kálmán-díjjal ismert el. Munkája során műszeres eljárásokat tervez, fejleszt növényi hatóanyagok méréséhez. Munkacsoportokat vezet és tudományos publikációkat közöl szakmai platformokon.
Készítette:
Oláh Tibor
Tulajdonos: MTI/MTVA
Fájlnév: BC__OB202102170018
Láthatóság:
publikus
Kiadás dátuma: 2021-02-18
Technikai adatok:
Bitmélység: 8
Tájolás: horizontal
Szélesség (px): 4000
Magasság (px): 3565
Forrás típusa: JPG
Azonosító: 0e01a930-da66-4193-9672-3824fccf217d
Tisztelt Felhasználónk! Ez a fénykép nem képezi a Nemzeti Archívum szerves részét. A kép tartalmáért és a szövegért a fotó készítője vállalja a felelősséget.
Legyen a szerkesztőnk!
Ha több információt tud a képről, mint az eredeti képszöveg, ossza meg velünk!